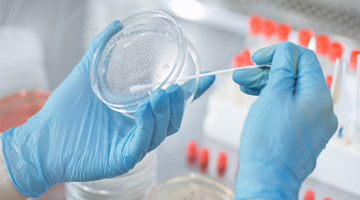

通过成分分析,对目标样品的基础组分进行分析,提供目标样品的成分分析报告。

通过成分分析,对目标样品的有效成分组分进行分析,提供有效成分分析报告。

通过成分分析,对指定的具体化合物或者化合物类型进行定性定量测试。

对目标样品的违禁物添加进行研究分析,提供目标样品的违禁物检测报告或是研究报告。
对产品或原材料大致成分进行分析,以满足成分备案的需求。

对目标样品中含量较大的化学组分进行定性/定量测试,提供主成分分析报告。